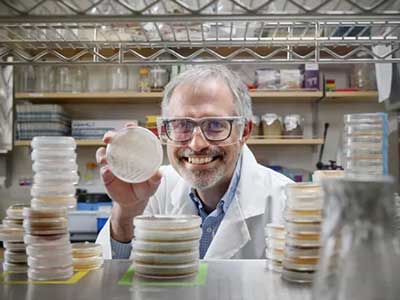
A man in a scientific labcoat smiles holding a petree dish.

There’s Only ONE
There’s OnlyONE
There’s OnlyONE











Researched & developed entirely within the state of Oklahoma.